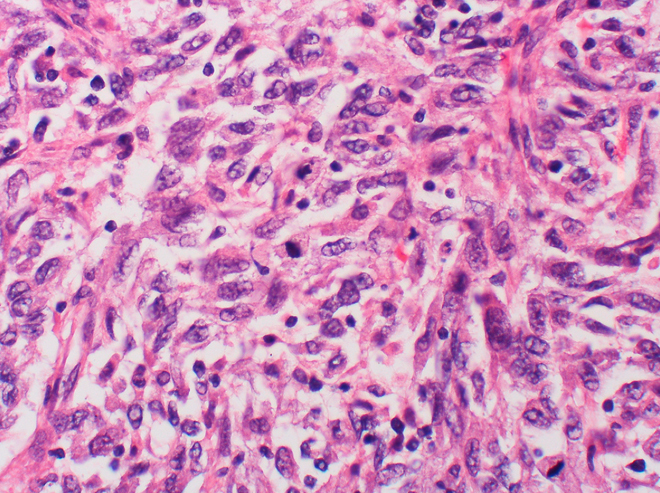

还在谈创新吗?牛叉叉的10家公司在这里:
借着我们上篇谈创新的文章,这里推荐10家真正可能对社会产生深刻变革的公司,译自《连线》:
PayPal联合创始人Max Levchin前阵子宣布他要在数字支付中再掺一脚再立门户,结果引来一片骂声。原因很简单,Max Levchin、Peter Thiel和硅谷的其他几个名人此前就公开吐槽科技行业止步不前、缺少颠覆性创新。结果也就一年多的功夫, Levchin自己又啃起老本做起支付,这当然不能算是雄心壮志。
尽管Levchin本人没有向那些伟大而令人恐惧的创新(即此前我们提到的moonshot)致敬,不过下面的这10家公司则跃跃欲试。这些公司的技术既不是让你去分享照片、也非给你推下一单交易,相反,这些公司解决的都是些“很硬很硬”的问题,并有可能对这个世界产生深刻的变革——而不是像另外一些公司一样,为了向你兜售他们的解决方案,硬是自己编造了一些用户痛点。我并不是说照片分享不好,只是,它跟这些公司要做的事情比起来,着实算不上伟大。
假如有家公司声称要“造架机器读懂人在想什么”,你觉得这个idea还不够牛叉、不够醍醐灌顶么?尽管这家公司目前生产的脑电波扫描仪还只是打游戏时用的控制器,不过他们的出发点已经算得上“雄心勃勃”。况且,当你开始谈论用大脑控制轮椅的时候,你还觉得它是花拳绣腿么?
Immumetrix
做Immumetrix的这个家伙还只是一个毕业生。这名乳臭未干的科学家Christina Fan研发出了一种测试胎儿唐氏综合症的新方法——只需对母体的血液做简单测试,即可替换此前更具风险、也更让人不爽的羊膜穿刺术。目前,她跟同事正在努力优化这个方法,并试图利用高速的DNA测序技术分析个体的免疫系统,用以开发最终的定制疗法。
Fan这样说道:“在遥远的未来,我们对免疫系统的认知将可用于基因工程领域,帮助人开发出超级免疫能力、或是对抗免疫障碍。”
要是我们对阴天和不刮风的天儿睁只眼闭只眼,那风能和太阳能确实不错。不过,17岁就从大学毕业的神童Danielle Fong却开发出了一种新方法来存储绿色能源,将整个用电效率提了一个档次。碰到用电高峰期,她的系统可利用压缩空气和水雾将电输送回电网。Peter Thiel, Vinod Khosla和Bill Gates等人已经投了不止3700万美元到这家位于伯克利的公司。
华为
这家公司貌似跟名单中的其他公司格格不入,为何入列?华为早年只是引入香港手机、现在却一跃成为电信巨头、以及世界领先的智能手机生产商。它的发家史可能在美国还不是广为人知,但它的成功实际不是因为它的手机有什么功能、而恰恰是因为它的手机不具有什么功能。
此话怎讲?华为的低价安卓机让智能手机在中国和其他国家不再成为价格高昂的奢侈品、而更趋向于普通商品。最近的一项评估就表明,现在世界上有差不多七分之一的人在使用智能机。想想看,假如剩下的那60亿人口也在使用智能机,会是什么一种情况?
M-PESA/Safaricom
在发展中国家的很多地区,因为缺少相应的电信网络支撑,信用卡和借记卡从未起步。不过,那些地区的手机却被使得很猛,所以也就出来一个词叫“大跨越”(leapfrogging)。因为人人都可以使用手机,那些支撑传统银行卡交易的电线也就可以被跳过。
肯尼亚的移动运营商Safaricom就开发出了一种名为M-PESA的服务,该服务允许用户通过手机短信直接完成转账和小额贷款——连银行账户都不用。跟美国这样的国家不同,因为M-PESA,移动支付在肯尼亚已经扬眉吐气,目前已有成千上万的用户。现在,Safaricom也在筹备将服务推广到其他缺少资金和技术设施支持的国家。
节能是件好事,让我们不费脑筋地节能就更好了。实际上,我们自己住的房子就是温室气体的最大排放源之一。好在,Nest的智能温控器可以通过学习用户习惯,自动控制室内温度,降低二氧化碳排放。
Organovo
设计软件巨头Autodesk最近刚跟Organovo联手,琢磨着要让机器直接打印计算机设计的人类器官。而实际上,Organovo的3-D生物打印机已经被医疗研究人员用于打印实验用途的组织。不仅如此,Organovo的联合创始人随后还一鼓作气成立了新公司Modern Meadow,专门研发可打印的肉类和皮革。
Plexxikon
在与癌症的斗争中,很少有家公司跟Plexxikon一样功勋卓著。这家公司研发出的一种化合物在对抗某个在晚期黑色素瘤中频发的突变时(以下为显微镜下的图片)效果显著。所以,下一次你再因为工作不顺心说出“癌症很可能无救”的话自嘲时,别忘了这家公司。
Oxitec
在世界上的很多地区,蚊子依然是传染性疾病最致命的载体之一。Oxitec的解决方案将一直致命基因注入到蚊子体内,然后它的下一代已经遗传该基因的幼虫会在成年前就死去。Oxitec这种控制整个物种的做法已经让人担心引发难以预期的生态危机,不过说实在的,假如Oxitec那些被改造的蚊子持续消灭疾病,那么将基因工程用于医疗的做法很有可能会越发普遍。
忘了我们开头提到的moonshot(登月)吧,你觉得登陆火星怎么样?在Paypal黑帮的所有成员中(这些人就包括Levchin和Thiel),Tesla和SpaceX的创始人Elon Musk玩创新才叫玩大的。这家伙不仅要把人送到火星上,他还希望我们当中的8万人可以直接在火星殖民,而SpaceX就是他的跳板。
于此同时,这家公司也在忙着实现私人太空旅行。最最近的时候,SpaceX就秀了一架垂直升空又垂直着陆的“火箭”——跟所有科幻电影里的桥段一样,另一架SpaceX飞船也完成了与国际空间站的对接。